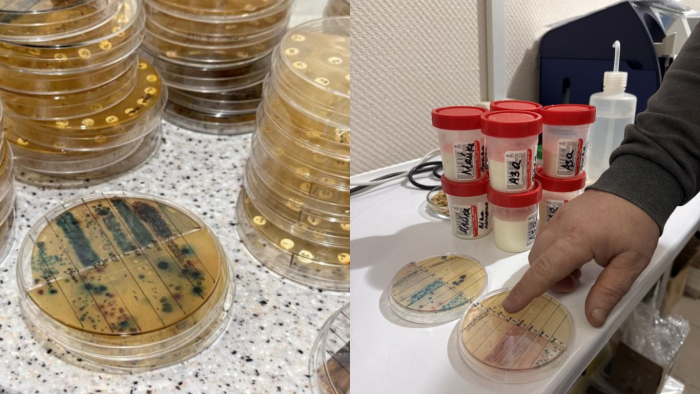

Тетяна Петлюх — жителька с. Малі Сорочинці на Полтавщині, яка разом із чоловіком Станіславом з 1995 року розвиває сімейне господарство. Після спроб у різні напрямках діяльності, вони зрештою зосередилися на розведенні ВРХ та підвищенні якості продукції. Сьогодні сім’я утримує 3 корови та молодняк.
Війна стала серйозним викликом для розвитку господарства: подорожчання кормів та перебої з електропостачанням суттєво впливають на операційну діяльність та мотивацію до роботи. Участь у програмі «Підтримка виробництва молока з доданою вартістю селянськими господарствами», що реалізується за підтримки Уряду США через Програму АГРО, яку впроваджує Консультаційний центр АВМ (КЦ АВМ), забезпечила доступ до сучасних знань у сфері ветеринарії, технологій виробництва та годівлі тварин і надихнула на подальший розвиток.
Завдяки впровадженню отриманих практик і супроводу фахівців, господарству Петлюх вдалося налагодити виробничі процеси та контроль якості молока і продукції, яку сьогодні постачають безпосередньо споживачам — від сиру й сметани до ряжанки та інших виробів.
«Візити ветеринарів дають змогу тримати відтворення під постійним контролем, — розповідає фермерка. —Проведення УЗД стало дуже важливим етапом. Ми вчасно визначили тільність корів і правильно їх запустили. Також одна корова виявилася яловою. Після консультації її пролікували та успішно осіменили. Завдяки своєчасному втручанню вдалося зберегти тварину, яку раніше планували вибракувати. Наразі вже дві корови отелилися, і ще очікуємо приплід від однієї».

Микола Базавлук, ветлікар КЦ АВМ під час візиту на сімейну ферму Петлюхів
У годівлі господарство отримало практичні знання для правильного розрахунку раціонів. Технологи КЦ АВМ неодноразово пояснювали та супроводжували процес, і це дало результат — зросли надої та покращилася якість молока.
«У нас була первістка, яка стала найпродуктивнішою за весь мій досвід: спочатку вона давала до 28 л молока, а після другого отелення — вже понад 40 л на добу. Такий результат, зокрема, вдалося отримати завдяки корекції годівлі: ми збільшили частку білку в раціоні — раніше цього остерігалися, але після консультацій усе було чітко прораховано», — розповідає пані Тетяна.
Також вона згадує випадок, коли в однієї корови спостерігалася «тиха охота» через надмірне годування. Після корекції раціону, рекомендацій фахівців і проведеного лікування тварина успішно запліднилася.
«Навіть маючи майже 30 років досвіду, постійно переконуєшся: завжди є що вдосконалювати і чому вчитися. Навчальні вебінари від КЦ АВМ допомагають оновлювати знання та впроваджувати практичні рішення», — підсумовує фермерка.
У межах програми, за підтримки юридичного супроводу в питаннях оренди земель для сінокосіння та випасання худоби, подружжя Петлюхів змогло оформити до 2 га сіножатей. Ділянка наразі майже повністю у воді, тож щойно підсохне — планують засіяти еспарцет разом із ячменем.
«Маємо власний трактор, культиватор, плуг і сівалку. Ще з 2017 року намагалися оформити цю ділянку, але постійно щось заважало: то не було вільної землі, то реєстри були закриті, відмовляли, а згодом і війна внесла свої корективи. Мій чоловік, Станіслав, займається заготівлею кормів. Фактично все тримається на ньому. Цього року нам став у пригоді і допомагає в кормозаготівлі прес-тюкувач, наданий на кооператив Програмою АГРО», — зауважує фермерка.
Ще одним важливим інструментом у роботі стали лабораторні дослідження в UmanLabs. На початку зими господарство відправило зразки молока для визначення збудника маститу та його чутливості до антибіотиків, що дозволило перейти до індивідуально підібраної схеми лікування. Ветеринар КЦ АВМ, спираючись на результати аналізів, надав чіткі рекомендації. Після їхнього впровадження мастит не турбує вже понад два місяці. Раніше антибіотики підбирали навмання, що не завжди давало результат.
Лабораторний аналіз зразків молока учасників проєкту в Uman Labs
Підсумовуючи, завдяки експертам КЦ АВМ сьогодні сімейна ферма Петлюхів із Полтавщини системно працює над підвищенням ефективності виробництва, зокрема:
У майбутньому на господарстві прагнуть розвивати сучасне виробництво: сформувати стадо з генетично сильних корів, оновити приміщення та посилити механізацію, щоб полегшити щоденну працю. Це дозволить підвищити ефективність і продемонструвати, що сільське господарство може бути сучасним, перспективним і привабливим для молоді.
Віра у свою справу та надія на перемогу України щодня додають сил фермерам і багатьом українцям по всій країні. Дякуємо Збройним Силам України за можливість працювати, жити й планувати майбутнє.
Консультаційний центр АВМ